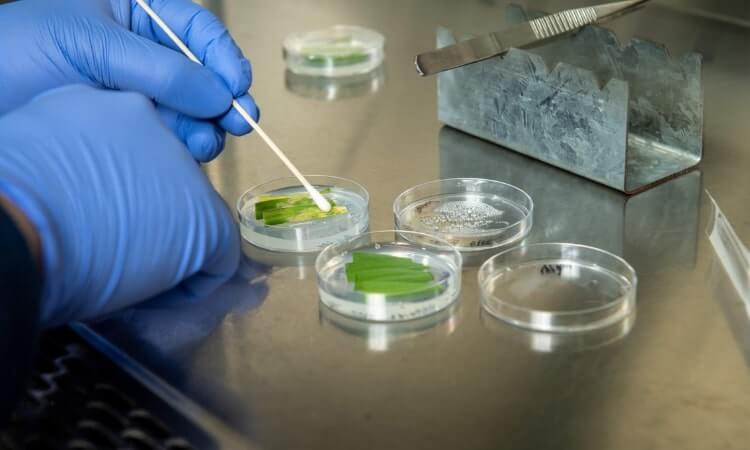
A person wearing gloves performs a plant tissue culture in a laboratory setting.

A key research focus of the Centre for Crop Health is management of soil-borne and foliar diseases of crops using genetic, genomic, phenotypic and pre-breeding approaches. The aim of our projects in this area is to reduce the economic impact that these diseases have in Australian farming systems and to broaden the scientific knowledge of the causal agents, including crop pathogenic fungi, bacteria, nematodes, and viruses and viroids
Title: National Variety Trials (Pathology) 2019 - 2024
Project Team: Dr Jason Sheedy | Dr Cassy Percy | Associate Professor Anke Martin
Project Partners: Agriculture Victoria | Department of Agriculture and Fisheries, Queensland | Plant Breeding Companies
Funding Body: GRDC
The National Variety Trials (NVT) program is the largest independent co-ordinated trial network in the world. The program assists Australian grain growers in varietal decision making by providing comparative information of commercially available grain varieties, including: yield performance, disease resistance ratings, and grain quality.
Australian chickpea breeding programs have identified the improvement of root lesion nematode genetic resistance as a priority. The project focuses on mapping the genetic location of genes contributing to resistance of two root lesion nematode species in cultivated chickpea and wild Cicer genotypes.
Title: Economic impact of root lesion nematodes in mungbean
Leader: Dr Jason Sheedy
Project Team: Neil Robinson
Funding Body: GRDC
Root lesion nematodes are widespread throughout the grain growing areas of the Northern region where these pathogens have been found in up to 77% of tested paddocks. The aim of the project is to determine the resistance and tolerance status of the commercially available mungbean varieties and the economic impact of these pathogens in mungbean production.
Title: Improving powdery mildew management in mungbean
Leader: Professor Levente Kiss
Project Team: Dr Kirsty Owen | Neil Robinson
Funding Body:
GRDC
Powdery mildew is a disease that impacts mungbean crops annually and if left unmanaged, and the environmental conditions are conducive to the disease, it can cause yield losses of up to 40%. With little genetic resistance in current varieties, management relies on the application of fungicides. A decision support tool (PowderyMildewMBM) is available to help guide fungicide application decisions and the likely economic returns from those actions. The project delivers a new set of validation trials and actively engages agronomists and growers with in-field disease management utilising the outputs of the decision support tool.
Title: Root Lesion Nematode resistance screening
Screening the field tolerance and greenhouse resistance reactions of nominated CAIGE Bread Wheat lines to the root lesion nematode Pratylenchus thornei.
Title: Mechanisms on resistance towards DMIs in grape powdery mildew
Leader: Professor Levente Kiss
Project Team: Dr Sadegh Balotf
Project Partners: Curtin University
Funding Body: BASF
The aim of the project is to determine the sensitivity or resistance levels of grape powdery mildew populations to DMI fungicides in Australian vineyards.
Title: Australian Fungicide Resistance Extension Network (AFREN)
Leader: Curtin University | Australian Fungicide Resistance Extension Network
Funding Body: GRDC
AFREN has been established to develop and deliver fungicide resistance resources for grains growers and advisers across the country. It brings together regional plant pathologists, fungicide resistance experts and communications and extension specialists. A team at CCH, led by Prof Kiss, is a partner of AFREN.